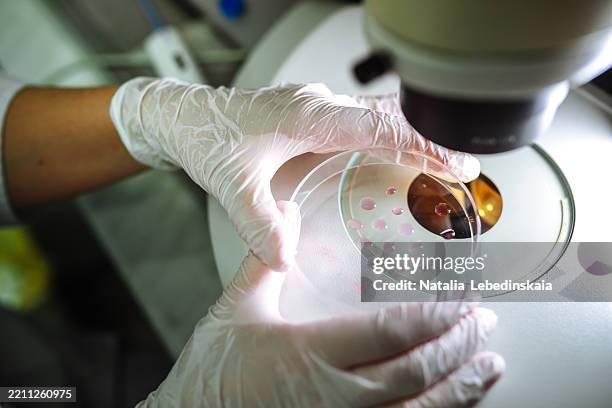
ivf process verification - skilled hands in medical gloves position dishes for inspection - petri dish stock pictures, royalty-free photos & images

bacteriamicroscopetest tubessciencedog bagbacteria petri dishpetri dish iconpetri dish white backgroundscientist petri dishpetri dish on whitepetri dish isolatedpetri dish from abovepetri dish vectorempty petri dishpetri dish handholding petri dishscience petri dishlab petri dishpetri dish abstracthand holding petri dishvirus petri dishpetri dish overheadplant petri dishpetri dish top viewpetri dish close uppetri dish dnabacteria in petri dishpetri dish black backgroundpetri dish leafpetri dish on black
12,286 Images and Stock Photos
View petri dish videos
Browse 12,286 authentic petri dish stock photos, high-res images, and pictures, or explore additional bacteria or microscope stock images to find the right photo at the right size and resolution for your project.


Related searches:

of100NEXT